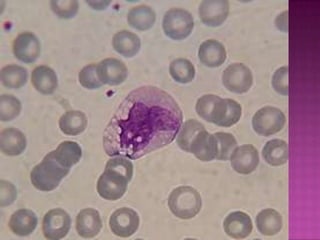
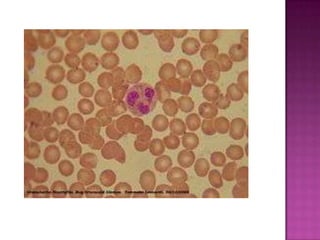

Los glóbulos blancos u leucocitos son células sanguíneas que se originan en la médula ósea y tejido linfático, y son los efectores de la respuesta inmunitaria. Se clasifican según la forma de su núcleo en mononucleares como linfocitos y monocitos, o polimorfonucleares como neutrófilos, basófilos y eosinófilos. Cada tipo de glóbulo blanco tiene funciones específicas como la fagocitosis de bacterias, regulación de la respuesta alé